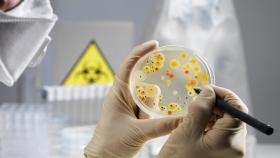
РСХН расследует нарушение санитарных норм ЕС российскими производителями

Башкирия выиграла 7 медалей на медовом конгрессе «Апимондия» в Канаде
Пчеловоды Башкирии взяли семь медалей на международном медовом конгрессе «Апимондия» в Канаде, и следующий его съезд пройдет в России, сообщает ТАСС.
Производители меда из российской республики уехали домой с двумя золотыми, двумя серебряными и тремя бронзовыми наградами. Жюри конкурса назвало лучш...
 главное сегодня:
главное сегодня: